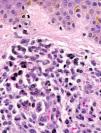
f0015

Varón de 75 años de edad, con antecedentes de hipertensión arterial, consultó por lesiones asintomáticas de un mes de evolución en cara y tronco. Además refería pérdida de 10 kilogramos de peso en el último año.
Exploración físicaSe apreciaron múltiples nódulos eritematosos de 2 a 4cm de diámetro, consistencia firme, localizados en el área facial (facies leonina), el cuero cabelludo, el cuello, el tronco y la zona proximal de extremidades (fig. 1). No presentaba afectación de mucosas. Se palparon adenopatías inguinales pequeñas y desplazables, sin hepatoesplenomegalia.
HistopatologíaLa epidermis no mostró alteraciones significativas. En dermis, respetando una banda de dermis papilar, se observaba un infiltrado difuso de células que se disponían entorno a vasos y anejos, y disecaban las fibras de colágeno (fig. 2). Las células eran grandes con citoplasma basófilo, núcleo vesiculoso, en ocasiones arriñonado, y nucleolo pequeño. Se observaron frecuentes figuras de mitosis (fig. 3). Inmunohistoquímicamente, dicho infiltrado era intensa y globalmente positivo para CD68 y lisozima, de forma focal para mieloperoxidasa, antígeno leucocitario común y CD34 y negativo para CD117 y factor viii.
Exploraciones complementariasEn el hemograma demostró la presencia de una leucocitosis (39.600leucocitos/μl con 56,2% de neutrófilos, 23,1% de linfocitos, 17,9% de monocitos, 1% de eosinófilos y 1,9% células grandes no teñidas) y una plaquetopenia (89.000plaquetas/μl). El frotis de sangre periférica demostró presencia de neutrófilos hipersegmentados. La punción aspiración de médula ósea resultó masivamente infiltrada por células de estirpe monocítica, un 20 a 30% de monoblastos y un 65% de promonocitos-monocitos. El estudio mediante hibridación in situ fluorescente mostró un 70% de células con trisomía del cromosoma 8.
DiagnósticoLeucemia cutánea (LC) en un paciente con leucemia monocítica aguda (LMoA) (M5b en la clasificación franco-americano-británica [FAB]).
Evolución y tratamientoEn el primer mes de tratamiento quimioterápico con etopósido a una dosis diaria de 50mg se obtuvo mejoría parcial de los nódulos faciales.
ComentarioLa leucemia suele causar lesiones cutáneas reactivas inespecíficas, en las que no se detectan células tumorales. Menos de un 10% de los pacientes presenta lesiones por infiltración leucémica en la piel, lo que se ha denominado LC. Esta indica un estadio avanzado, con un tiempo medio de supervivencia menor de un año. Su aparición es posterior o simultánea al diagnóstico hematológico. Cuando no se identifica alteración en sangre periférica o en médula ósea se habla de leucemia cutánea aleucémica1. El tratamiento de la LC es el de la leucemia subyacente, aunque puede asociarse radioterapia para resolver las lesiones cutáneas2.
La LMoA es un subtipo leucemia mieloide aguda (LMA), M5 de la clasificación FAB. Es la leucemia que con mayor frecuencia desarrolla LC (10–33%). Se divide en M5a y M5b en función de si los elementos de la serie monocítica son monoblastos en más o menos del 80% respectivamente3. Algunas anomalías cromosómicas, como la trisomía 8, son comunes en los pacientes con LC4.
Las manifestaciones cutáneas de la LC son muy variadas. Es característica la aparición en menos de 1 mes de múltiples pápulas o nódulos asintomáticos, firmes y eritemato-violáceos. Tiende a afectar cabeza (puede adoptar aspecto leproide)5, cuello, tronco y piernas o a infiltrar zonas sometidas a traumatismos y en cicatrices previas (por quemaduras o infección herpética). No es rara la hiperplasia gingival2–4,6.
El patrón histológico de la LC depende del tipo de leucemia implicada. En las LMoA, se observa un infiltrado difuso de células tumorales que invade toda la dermis y en ocasiones hipodermis, con tendencia a disponerse alrededor de vasos y anejos. Suele ser más denso en la dermis alta y disecar fibras de colágeno y destruir vasos y anejos en profundidad. Epidermis y dermis papilar suelen estar respetadas. El infiltrado es bastante monomorfo, constituido por células de gran tamaño, con citoplasma eosinófilo y núcleo vesiculoso oval; asimismo es frecuente observar figuras mitósicas2,4.
Dada la gran variabilidad clínica el diagnóstico diferencial es muy extenso. Hay presentaciones atípicas que simulan dermatosis de posible aparición en el contexto de una leucemia como erupciones cutáneas medicamentosas, infecciones oportunistas (sobre todo fúngicas o vírales), eritema elevatum diutinum, síndrome de Sweet, vasculitis leucocitoclástica aguda, enfermedad injerto contra huésped, eritema nudoso y pioderma gangrenoso. Es necesaria una confirmación histopatológica para establecer el diagnóstico de LC. Histopatológicamente puede confundirse, requiriendo estudios inmunohistoquímicos, con linfoma, hematopoyesis extramedular, carcinoma anaplásico, sarcoma de Ewing, neuroblastoma, carcinoma de células de Merkel, metástasis cutáneas, melanoma y proliferaciones histiocíticas4,7.
Conflicto de interesesLos autores declaran no tener ningún conflicto de intereses.